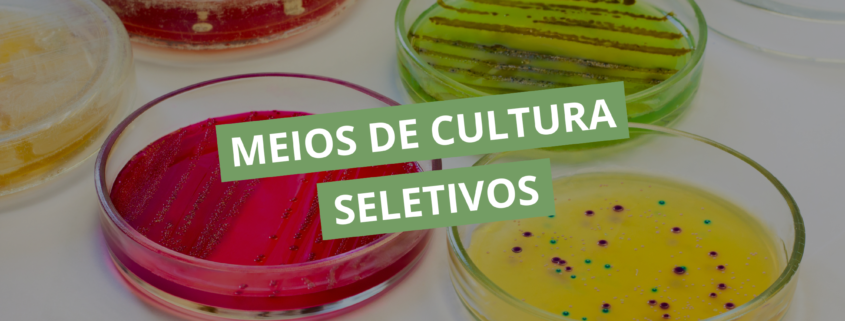

Meios de cultura seletivos
Os meios de cultura são ferramentas centrais na microbiologia, permitindo o isolamento, o crescimento e a identificação de microrganismos a partir de diferentes tipos de amostras. Entre eles, os meios de cultura seletivos possuem papel estratégico, pois favorecem o crescimento de determinados grupos microbianos enquanto restringem ou inibem o desenvolvimento de outros.
A compreensão detalhada dos princípios de seletividade e de suas aplicações é essencial para garantir a precisão e a confiabilidade dos resultados microbiológicos.
Conceito de meios de cultura seletivos
Meios de cultura seletivos são formulados com agentes inibidores específicos, capazes de restringir o crescimento de microrganismos indesejáveis presentes na amostra, permitindo que o grupo de interesse se desenvolva de forma predominante.
Diferentemente de meios simples ou enriquecidos, que apenas fornecem nutrientes adequados ao crescimento microbiano, os meios seletivos introduzem um fator de pressão ambiental que atua como filtro biológico. Apenas microrganismos com determinadas características fisiológicas ou estruturais conseguem se multiplicar nesse ambiente.
Princípios da seletividade microbiana
A seletividade de um meio está relacionada à resistência intrínseca ou adquirida de determinados microrganismos aos agentes inibidores presentes. Esses agentes podem atuar de diversas maneiras, como:
- interferindo na integridade da parede celular;
- alterando a permeabilidade da membrana;
- inibindo vias metabólicas essenciais;
- criando condições osmóticas ou de pH desfavoráveis.
Enquanto alguns microrganismos são inibidos, outros se desenvolvem normalmente, tornando-se mais facilmente detectáveis.
Tipos de agentes seletivos utilizados
Entre os principais agentes seletivos, destacam-se:
Sais biliares
Comuns em meios destinados ao isolamento de bactérias entéricas, atuam principalmente na inibição de bactérias Gram-positivas.
Corantes
Substâncias como cristal violeta ou verde brilhante interferem na estrutura celular de microrganismos sensíveis, restringindo seu crescimento.
Antibióticos
Permitem a supressão direcionada de grupos microbianos específicos, preservando o crescimento do agente de interesse.
Alta concentração de sal
Criam um ambiente osmoticamente desfavorável para a maioria das bactérias, selecionando microrganismos halotolerantes.
Ajustes de pH
Alguns microrganismos toleram apenas faixas específicas de pH, o que pode ser explorado como fator seletivo.
Importância dos meios seletivos
Em amostras que contêm diversos microrganismos, espécies de crescimento rápido podem sobrepor microrganismos de interesse, dificultando seu isolamento.
Os meios de cultura seletivos permitem:
- facilitar o isolamento do microrganismo-alvo;
- reduzir a interferência da microbiota acompanhante;
- aumentar a sensibilidade do cultivo;
- otimizar a interpretação das culturas;
- melhorar a eficiência e a confiabilidade do fluxo laboratorial.
Esses fatores tornam os meios seletivos indispensáveis tanto na microbiologia básica quanto na aplicada.
Exemplos clássicos de meios seletivos
Ágar MacConkey
Contém sais biliares e cristal violeta, inibindo bactérias Gram-positivas e permitindo o isolamento de bacilos Gram-negativos entéricos.
Ágar Manitol Salgado
Apresenta elevada concentração de cloreto de sódio, favorecendo bactérias halotolerantes, como espécies do gênero Staphylococcus.
Ágar Cetrimida
Contém cetrimida, que favorece o crescimento de Pseudomonas aeruginosa, inibindo outros microrganismos.
Ágar Thayer-Martin
Enriquecido com antibióticos, é utilizado para o isolamento de Neisseria em amostras com microbiota contaminante.
Relação entre meios seletivos e meios diferenciais
Embora alguns meios combinem ambas as funções, seletividade e diferenciação são conceitos distintos:
- Meio seletivo: determina quais microrganismos conseguem crescer.
- Meio diferencial: permite distinguir microrganismos com base em reações bioquímicas visíveis, como mudança de cor no meio ou nas colônias.
A combinação de ambos aumenta a eficiência do isolamento e a riqueza de informações obtidas em laboratório.
Os meios de cultura seletivos são ferramentas fundamentais na microbiologia, garantindo o controle do crescimento microbiano e facilitando o isolamento de microrganismos específicos. O domínio desses princípios permite uma prática microbiológica precisa e eficiente, potencializando a confiabilidade e a interpretação dos resultados laboratoriais.
Amplie seu conhecimento e aprofunde-se na microbiologia clínica. Descubra técnicas avançadas de isolamento, identificação e interpretação de microrganismos e fortaleça sua prática laboratorial com a nossa Pós-graduação em Microbiologia Clínica.